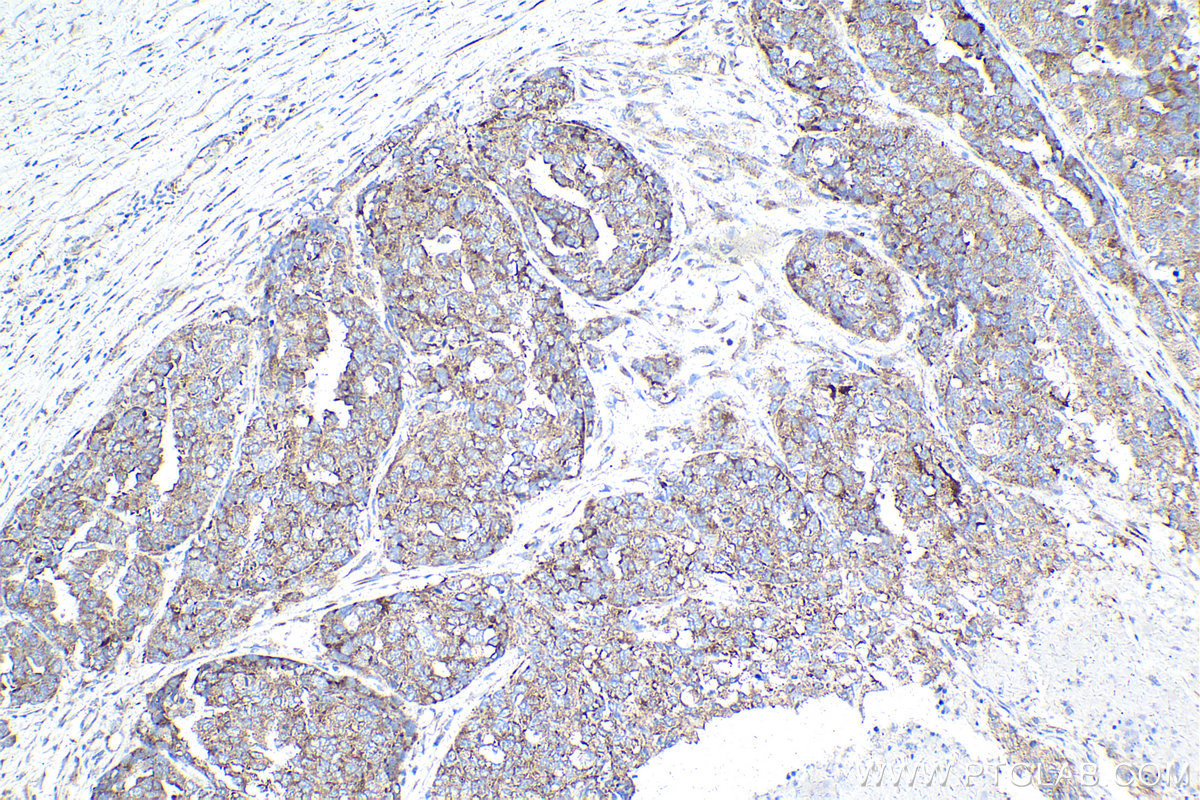

验证数据展示
产品信息
68518-1-PBS targets PRKRA in WB, IHC, Indirect ELISA applications and shows reactivity with human, mouse, rat samples.
| 经测试应用 | WB, IHC, Indirect ELISA Application Description |
| 经测试反应性 | human, mouse, rat |
| 免疫原 |
CatNo: Ag29818 Product name: Recombinant human PRKRA protein Source: e coli.-derived, PET28a Tag: 6*His Domain: 1-160 aa of BC009470 Sequence: MSQSRHRAEAPPLEREDSGTFSLGKMITAKPGKTPIQVLHEYGMKTKNIPVYECERSDVQIHVPTFTFRVTVGDITCTGEGTSKKLAKHRAAEAAINILKANASICFAVPDPLMPDPSKQPKNQLNPIGSLQELAIHHGWRLPEYTLSQEGGPAHKREYT 种属同源性预测 |
| 宿主/亚型 | Mouse / IgG2b |
| 抗体类别 | Monoclonal |
| 产品类型 | Antibody |
| 全称 | protein kinase, interferon-inducible double stranded RNA dependent activator |
| 别名 | PACT, Interferon-inducible double-stranded RNA-dependent protein kinase activator A, HSD-14, HSD14, HSD 14 |
| 计算分子量 | 34 kDa |
| 观测分子量 | 34 kDa |
| GenBank蛋白编号 | BC009470 |
| 基因名称 | PRKRA |
| Gene ID (NCBI) | 8575 |
| 偶联类型 | Unconjugated |
| 形式 | Liquid |
| 纯化方式 | Protein A purification |
| UNIPROT ID | O75569 |
| 储存缓冲液 | PBS only, pH 7.3. |
| 储存条件 | Store at -80°C. The product is shipped with ice packs. Upon receipt, store it immediately at -80°C |
背景介绍
PRKRA (PKR-associated protein X) is also named as PACT, RAX, HSD-14 and HSD14. PRKRA was significantly overexpressed in PC tissues and promoted the proliferation, migration, and chemoresistance of PC cells (PMID: 37484321). PRKRA activates EIF2AK2/PKR in the absence of double-stranded RNA (dsRNA), leading to phosphorylation of EIF2S1/EFI2-alpha and inhibition of translation and induction of apoptosis. PRKRA has been shown to interact with DICER1. DICER1 and PRKRA expression in normal colon was limited to mucosal epithelium and showed similar cytoplasmic expression (PMID: 37484321).